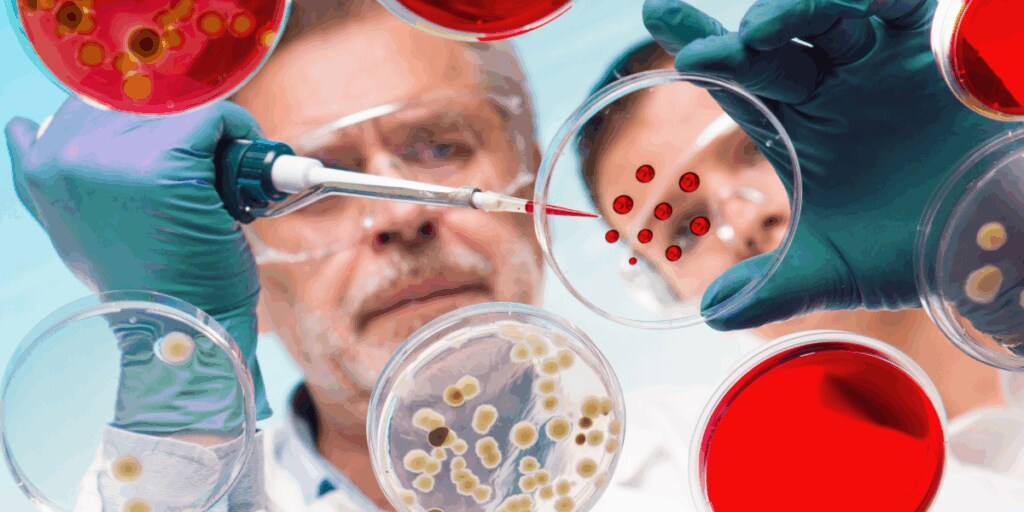

What is the best column for separating AAV size variants? The results are in, and the findings might surprise you.
Analysis of the Paper: “Systematic comparison of wide pore size exclusion chromatography columns for the characterization of gene therapy products” published by Matthias Buff et al. in Journal of Chromatography A.
In the evolving field of gene therapy, the characterization of adeno-associated viruses (AAVs) to assess certain critical quality attributes, like the presence of aggregates, is one crucial factor to help ensure these therapeutics are safe and effective.
Size-exclusion chromatography (SEC) is one proven and agreed-upon technique by the scientific community for separating AAV size variants, including aggregates. Key to this technique is using a column with the right pore size and pore volumes to separate AAV for the size variants.
The recent paper by the Matthias group presents a systematic comparison of six wide-pore SEC columns for separating AAVs and the corresponding aggregates.
Here are the top three takeaways from this comprehensive analysis, plus valuable method development considerations not explored in the study.
1. No universal “Best” column
The study emphasizes that there is no single “best” column for all AAV samples. The choice of the appropriate SEC column is highly dependent on the specific characteristics of the sample analyzed.
While all six columns tested showed competent performance in separating AAV monomers and dimers, the optimal choice varied based on sample-specific parameters. This finding underscores the importance of tailoring your column selection with the unique properties of each sample to achieve the best separation results.
Pro tip: One fast and simple way to pick the right column is to use a Method Development LC System to screen multiple columns at once (Figure 1).

Figure 1. Example of a method development LC system setup for screening multiple columns and eluents.
2. Monodisperse silica columns deliver high efficiency
Columns packed with monodisperse silica, such as the Thermo Scientific SurePac Bio 550 SEC MDi and the DNACore AAV-SEC demonstrated the highest efficiency in terms of plate counts.
This observation is particularly intriguing because, for small-molecule separations, current literature suggests that monodisperse packing beads do not necessarily lead to higher column efficiency. However, in the specific context of AAV separation, monodisperse silica columns can offer significant efficiency advantages because the packing beads are evenly dispersed, compared to polydisperse columns (Figure 2).
This data highlights the potential of these columns to improve the resolution and accuracy of AAV characterization, making them a valuable tool for the purification and analysis of gene therapy products.

Figure 2. SEM images showing the packing of 3 µm monodisperse silica particles (left) vs. 3 µm polydisperse particles (right).
3. Performance differences in peak positioning term (Q4)
One of the critical differentiators among the columns was the performance against the Peak Positioning Term (Q4) introduced by Fekete et al., which measures the pore size match to the target analyte.
The Q4 term is a crucial factor to consider in determining separation efficiency because the pore size directly impacts the ability of your column to separate AAV monomers from aggregates. In this work, columns such as the BiozendSEC-7 LC, AdvanceBio SEC 500A, and SurePac Bio 550 SEC MDi scored the highest in this metric, indicating these columns have the most suitable porosity for AAV samples.
These results support the theory that selecting a column with an appropriate pore size that closely matches the target AAV size is essential for achieving optimal separation.
Other considerations not studied for analyzing raw AAV aggregates
- AAV samples come in limited amounts. Samples may adsorb to the surface of the storage vessel, affecting recovery (Figure 3). Preserve recovery by choosing low-binding glass vials.
- Another factor affecting sample recovery is the column hardware. Best practice is to use inert column hardware to eliminate the loss of proteins in the column walls and frits.
- In SEC, resolution between aggregates and monomers markedly improves with decreasing mobile phase linear velocity. With the modern UHPLC SEC columns, you can work with short columns at low flow rates and still obtain relatively fast runs.
- Multi-angle light scattering (MALS) detection is the workhorse detection for SEC of AAVs, but it is not as sensitive as UV or fluorescence. If you run SEC-MALS, inject larger amounts of AAV to ensure the column you use does not lose resolution between monomers and aggregates.

Figure 3.SEC-FLD analysis of AAV in solution. Data shows the change in AAV concentration over 12 hours for a sample stored in plastic vials (left) versus glass vials (right).
Explore the latest techniques and technology for analyzing AAVs
The comparative study by Matthias Buff et al. provides valuable insights into the performance of different wide-pore size exclusion chromatography columns for AAV analysis.
The key takeaways highlight the importance of sample-dependent column selection, the efficiency benefits of monodisperse silica columns, and the significance of pore size match in achieving optimal separation.
These findings can guide separation and lab scientists in selecting the most suitable SEC columns for their specific AAV characterization needs, ultimately contributing to the advancement of gene therapy research and development.
Want to learn more about using AA-SEC aggregate analysis? Watch our on-demand webinar featuring the SurePac Bio 550 SEC MDi column evaluated in the peer review study.
Additional learning resources
Size-exclusion chromatography of adeno-associated viruses with the SurePac Bio 550 SEC MDi column
SurePac Bio 550 SEC MDi HPLC Column catalog
FAQ
What are the methods for purifying AAVs?
Purifying AAVs is a multi-step process. Analytical techniques involve HPLC analysis to characterize and quantify target AAVs. Size exclusion chromatography (SEC) allows you to separate size variants and aggregates. Affinity or strong ion-exchange chromatography (IEX) helps you purify target AAVs by separating empty from full capsids.
Visit us on LinkedIn: #AAV #oligo #SEC #genetherapy



